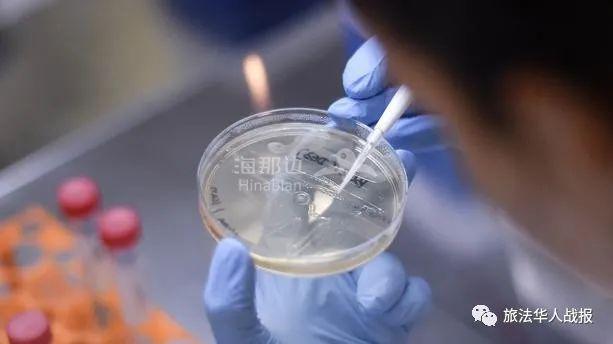
..

(点击图片,加入移民交流群)
巴黎1月2日电(王琴明)截至2日下午,法国新冠肺炎确诊患者达2643239例,24小时内新增3466例;病亡患者为64921例,增加157例。
(点击图片,加入移民交流群)
【英国疫情加剧,启动方舱医院,关闭小学】
自12月31日以来,英国大部分地区已被重新封禁。据路透社2日消息,过去4天,英国每日新增确诊病例均超过5万例。英国正在面对新冠疫情再度爆发,部分病例与一种传染性更强的新毒株有关。
英国已重新启动在新冠疫情开始时建立的方舱医院,并在周五(1日)关闭伦敦各小学,以应对传染性更强的变异新冠病毒的快速传播。
(点击图片,加入移民交流群)
教育部长加文·威廉姆森(Gavin Williamson)表示:“儿童的教育和福祉仍然是国家优先考虑的问题。”他解释道,“转向远程教育是收关的解决方案。”
关闭小学这一决定是在几家英国医院担心住院儿童人数不断增加的情况下做出的。在接受BBC采访时,伦敦国王学院医院主任劳拉·杜菲尔(Laura Duffel)提到了专门收治新冠儿童的医院已经人满为患。儿童病例的爆发与新毒株有关。
(点击图片,加入移民交流群)
英国会议中心等地点的方舱医院早已建成,但它们几乎没有使用过,一直处于待命状态。英国国家卫生服务局(NHS)的一位发言人说:“由于新的变异感染的蔓延带来了压力,伦敦国民保健服务系统被要求确保方舱医院被重新激活,并准备在需要时接纳患者。”
而自疫情开始以来,英国记录的累计死亡人数接近75000人。尽管已经为95万公民接种疫苗,在周五(1日)的收关24小时内该国记录了新增53285例病例,另有613例新死亡。
【专家和家长呼吁法国政府推迟开学】
由于新冠肺炎疫情回升,几个欧洲国家已经决定推迟小学开学,英国的疫情,特别是儿童感染数量上升的情况引发了流行病学专家的担忧。日内瓦大学全球健康研究所主任安东尼·弗拉奥(Antoine Flahault)教授在推特上表示:“我们不要犯与首要波疫情在意大利时开始爆发时相同的错误,不要在1月初重新开放学校。”
(点击图片,加入移民交流群)
“随着英国和爱尔兰的疫情恶化”,这位流行病学家敦促各国政府“不要在欧洲拖延疫苗接种,目前的当务之急就是加速疫苗接种。”
弗拉奥的看法获得了不少支持的声音。1月4日星期一,法国学生必须在两周的假期后返校,这两周的假期中他们经历了大量的家庭团聚和聚集活动。
法国流行病学家马哈茂德•祖雷克(Mahmoud Zureik)在《巴黎人报》的采访中遗憾地表示,“法国没有像德国那样推迟开学,对开学也缺乏防疫准备”。
许多欧洲国家确实决定将新学期推迟几天甚至几周开始,特别是英国的一些地区。包括希腊、波兰、爱尔兰、荷兰和奥地利在内的欧洲国家也推迟了开学。
法国学生家长组织“被遗忘的学校和家庭”谴责政府没有在新毒株在法国领土上出现后加强应对措施。
在周三写给政府的一封公开信中,这些家长要求,“鉴于疫情的死灰复燃、以及针对英国和南非出现的新冠病毒变种的巨大不确定性,希望学校不会在1月4日开学”。
他们在公开信中写道:“正如法国许多专家以及大多数欧洲国家所要求的那样,学生返校必须被推迟,以确保学校和学生的安全。”
他们认为推迟返校可以留出时间,对新出现的病毒新毒株和年末假期对疫情发展的影响进行评估。并且在开学前学校应该制定应对疫情的方案,比如减少在校人员,确保有效的通风,以及进行便捷的抗原测试等措施。
“如果任由疫情在学校传播,必将危及整个社会。不幸的是,我们将不得不共同为政府这种观望而不及时行动付出代价。去年3月份意大利伦巴第大区出现疫情后,政府不及时的观望态度,已经让我们付出巨大代价。”他们在公开信补充道。
【英国和南非2种病毒变体解析】
去年12月,法国发现了两种分别来自英国和南非的新冠病毒变种。这些新的突变似乎更具传染性,令卫生机构感到担忧。法国公共卫生部传染病部主任布鲁诺·克尼尔德(Bruno Coignard)向法新社解释道,“我们的目标是快速反应以避免出现继发病例,并放慢病毒传播速度来避免卫生系统压力过大。”
“没有证据表明病毒新变种有更高的致病性。另一方面,更高的传染性可能意味着更高的发病率,因此即使在同等死亡率下,也会给卫生系统带来更大的压力”,克尼尔德补充道。
(点击图片,加入移民交流群)
欧洲疾病预防和控制中心(ECDC)上周也警告称,最近发现的两种新冠病毒变种可以给卫生系统带来额外压力,也可以间接造成更高的死亡率。
来自南非的新冠病毒变种被命名为“501.V2”,12月30日,一名从南非返回并居住在瑞法边境的上莱茵省(Haut-Rhin)的男子被证实感染了“501.V2”病毒。
从南非回国后,由于该名男子出现疑似新冠的症状,在瑞士进行了核酸检测,检测呈阳性,又对该病毒进行了测序,证实了是10月份在南非发现的病毒变体。改变体导致了南非大多数新增病例,这些病例数每天还在急剧增加。南非新冠肺炎死亡人数超过2万8千人,是非洲大陆上死亡人数最多的国家。
据法新社报道,南非KRISP研究所所长多罗·奥利维亚(Tulio de Oliveira)称,在南非从11月下半月开始,测序的80%到90%的病毒都显示了这种变异。根据他的说法,“所有的因素都表明这个变种比以前的变种更具传染性”。
到目前为止,在英国、芬兰、瑞士和法国都发现了南非的变体。
(点击图片,加入移民交流群)
12月25日,在图尔,一名几天前从伦敦抵达的法国人确认携带英国新冠病毒变种“Voc 202012/01”。法国公共卫生部上周表示,12月30日在第二名曾在英国逗留的法国人身上也发现了这种病毒变种,但没有说明是在法国哪个地区。
今年9月在英国首次检测到这种变异,该病毒的基因组上有22个突变。其中一种名为“N501Y”的突变位于冠状病毒的刺突蛋白上,这是冠状病毒表面的一个点,它可以附着在人体细胞上,然后穿透细胞,因此在病毒感染中发挥关键作用。
与南非的变种一样,在英国进行的几项研究表明,英国的变种比原始菌株更具传染性。伦敦卫生和热带医学学院(LSHTM)的一名专家估计,这种传染性要高出“50%至74%”,这可能会对海峡对岸的法国的与新冠有关的死亡和住院人数产生影响。
伦敦卫生和热带医学学院的研究人员还指出,目前还没有证据表明这种变异会导致更严重的致病性,但这种变异可能导致的病例数量的“急剧增加”可能会对疫情的结果产生重要影响。
英国的变体已经在包括加拿大,美国,葡萄牙,约旦,韩国,智利和法国在内的多个国家被发现。
【新18点宵禁政策解析】
从今天(1月2日)开始,法国15个疫情特别严重的省将在下午6点实行提前宵禁。许多民众关心提前的宵禁政策对生活造成的影响。为此政府发言人加布里埃尔·阿塔尔(Gabriel Attal)在TF1电视台向民众解释道,“提前宵禁的政策虽然看起来复杂,但其实对人们生活的安排没有太大影响,我们的目标是在疫情严重的省份达到感染率下降的立竿见影的效果。”
政府发言人同时承诺政策有一定的“灵活性”,特别是考虑到本周末圣诞假期结束后的的大规模人口流动。然而,在受新政策影响地区生活的650多万民众,尤其是家长们,都对新宵禁抱有疑虑。
托儿所和学校:“一切都不会改变”
滨海阿尔卑斯(Alpes-Martimes)省长布鲁诺·胡贝尔(Bruno Huber)安慰家长们道,“对于未成年人的父母来说,一切都不会改变。孩子们正常去托儿所、幼儿园、小学、和中学。课程结束的时间也没有变化,即使有些课结束的时间超过下午6点也不受影响。就像从首要次封城之后开始的那样,家长们必须随身携带一份学校提供的出行证明。”
对于大学师生来说,宵禁的影响不大。“只有少数学生,特别是有残疾等困难的学生,才会回到学校上课。他们也必须带一份出行证明来应对检查。”布鲁诺·胡贝尔补充道。
课外活动
索恩-卢瓦尔省(Saône-et-Loire)在一份声明中明确表示,“下午6点以后的学校活动和课外活动依然可以照常进行”。政府还补充道,“在这种情况(下午6点之后的活动)下,儿童、学生、家长和学校校车司机的出行将属于‘职业活动、教育和培训’的豁免范围。”这一豁免也包括与学校活动和学习直接相关的课堂延伸活动”。
另一方面,普通民众的户外休闲活动必须在下午6点前结束,无论是在公共道路上散步或运动,在自然环境中做散步、运动、打猎、钓鱼等户外活动。对于学生的课外活动,在圣诞假期结束前,也就是直到1月3日,晚上8点之前可以安排活动。从1月4日起,课外活动必须在下午6点之前结束。
(点击图片,加入移民交流群)
仍然可以外卖
提前宵禁区的商店和服务业活动必须在下午6点关门。餐厅客人自行外带的活动也会在下午6点结束。另一方面,餐馆仍可进行外送活动。1月2日之前获得的豁免权将继续适用于新的宵禁。18点之后进行餐饮外送始终需要相关证明,这个证书可从政府网站、内政部网站或TousAntiCovid申请下载。总而言之,人们可以在下午6点后享用寿司或其它外卖食物。不受影响。